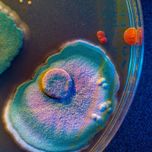
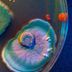

Share
Talking Techniques
Synthetic biology: from cancer to the climate crisis
In this episode, we explore the field of synthetic biology. Discover the history of the field and its origins in the production of biofuels, before fracking burst onto the scene forcing a pivot in direction towards chemical production. Find out about the key techniques that have brought synthetic biology into the realm of immunotherapies and cancer research, which have even welcomed in a return to applications focussed on tackling the climate crisis, such as lab-grown meat.
To investigate this space, I speak with Merrit Savener, Biopharma Technical Account Manager at Molecular Devices (CA, USA) and Adam Clore Technical Director of Synthetic Biology at Integrated DNA Technologies (IA, USA). Merrit and Adam provide their insight into the most exciting applications of synthetic biology, the regulation surrounding it, how they would wish to improve the field, revealing the true impacts that this field can deliver in addressing some of humanity's biggest issues.
- Introduction: 00:00-02:30
- Explaining synthetic biology: 02:30-03:45
- Origins of synthetic biology: 03:45-05:25
- Key current applications of synthetic biology: 05:25-07:30
- Key methods involved in synthetic biology: 07:20-09:30
- Challenges in synthetic biology for product production: 09:30-12:35
- Regulating synthetic biology: 12:35-14:55
- What would you change to improve synthetic biology? 14355-16:55
- Most exciting applications of molecular biology: 16:55-20:40
- The future of synthetic biology: 20:40-22:45
- Making electronics manufacturing more sustainable with synthetic biology: 22:45-23:15
- Changing perceptions in synthetic biology: 23:15-25:30
More episodes
View all episodes

The BRAIN miniseries | Investigating the link between vascular health and neurodegeneration in underrepresented populations
32:57|In our second episode of the BRAIN (Black Researchers Addressing Inequalities in Neuroscience) podcast miniseries, we explore the lab techniques and interdisciplinary approaches being leveraged to understand how vascular health impacts neurodegeneration, particularly in underrepresented populations. Our guest is Cellas Hayes, a neuroepidemiologist and postdoctoral researcher at Stanford University School of Medicine (CA, USA), whose work traverses brain aging, Alzheimer's disease and vascular health, with a particular focus on blood-based biomarkers, white matter disease and cognitive aging across diverse populations. Using large, deeply phenotyped cohorts, Cellas studies how different modifiable and cardiometabolic risk factors shape brain health long before clinical dementia emerges. Beyond research, Cellas is strongly engaged in mentorship, grant writing and building equitable pathways in aging and neuroscience research.
The BRAIN miniseries | Meet the neuroengineer building brain-monitoring devices and thriving communities
17:55|In our first episode of the BRAIN (Black Researchers Addressing Inequalities in Neuroscience) podcast miniseries, we dive into the research world of neuroengineering to gain an insight into the innovative devices being developed to monitor neurological disorders in addition to highlighting organizations that are playing a crucial role in supporting Black academics. Our guest is De-Shaine Murray, a Wu Tsai Institute Postdoctoral Fellow at Yale University (CT, USA), working at the intersection of biomedical engineering and neuroscience to make devices to monitor disorders such as traumatic brain injury, stroke and brain cancers. He is also interested in using these same techniques for sweat monitoring, women's health, and lab-on-a-chip applications. His academic career began at the University of Birmingham (UK) in chemistry, but has since moved into neurotechnology and bioengineering at Imperial College London (UK), the University of Cambridge (UK) and Yale. During that time, De-Shaine has been an instrumental community builder, founding organizations to support Black students in academia, participating in outreach and using his voice to create change in neuroscience.
Cytokine networks in autoimmune diseases: mechanisms, pathogenesis and therapeutic innovations
21:54|In this episode of Talking Techniques, Ritwika Biswas, Field Application Scientist at Sino Biological US Inc. (PA, USA), discusses the role of cytokines in autoimmune diseases, the techniques used to examine them and some emerging therapeutic innovations beginning to change the way we approach the treatment of autoimmune diseases.ContentsIntroduction: 00:00–02:06The role of cytokines in a healthy body: 02:06–03:57Cytokines in autoimmune diseases: 03:57–06:24Techniques for detecting cytokines in autoimmune diseases: 06:24–09:48Targeting cytokines for therapeutic purposes: 09:48–11:54Challenges with targeting cytokines in autoimmune diseases: 11:54–14:28Addressing the challenges of targeting cytokines: 14:28–16:43Established cytokine-targeting drugs: 16:43–18:57The future of cytokines in autoimmune diseases: 18:57–21:54
Skills-based teaching and microcredentialing in STEM
54:22|This episode of Talking Technique deviates slightly from specific lab technologies to instead discuss techniques and methods we use for teaching and testing life sciences.To do this, I’m speaking to two pioneers of unconventional teaching and testing approaches to STEM education. Angela Consani is the Co-Founder and CEO of the Bioscience Core Skills Institute (KS, USA). This skills-first microcredential program provides certification for lab skills in techniques, safety and quality control, using performance-based practical testing. Natalie Kuldell is the Founder and Executive Director of Biobuilder (MA, USA), a nonprofit organization, set up to increase interest, understanding and engagement in STEM by converting lab research projects in into teachable modules aimed primarily at the pre-graduate level to give students the practical skills needed for a career in the life sciences.Together, we’ll question the current system of STEM education and training and whether it captures all the potential talent that could be channeled into the life sciences, best serving all the roles available in the industry.Contents:Introductions: 00:00-03:00Introducing BioBuilder: 03:00-07:00What industry wants from skills-based testing: 07:00-11:25How well do current university degrees meet these requirements: 11:25-15:40Designing curriculums to meet the requirements of industry and updating life science education to meet the demands of a new world: 15:40-21:55The practicalities of a skills-based curriculum: 21:45-23:50Conducting skill-based testing: 23:50-28:40Testing BioBuilder’s curriculum: 28:40-32:00Can skills-based courses really provide the underlying knowledge needed to flourish in a career in STEM: 32:00-37:00How the biotech industry is responding to skills-based teaching and testing: 37:00-46:00The interplay between testing and learning and industry: 46:00-51:20Outro: 51:20-54:00
6. Antigen validation and T-cell receptor engineering for cancer immunotherapies
19:41||Season 5, Ep. 6This episode of the Talking Techniques podcast dives into the realm of cancer immunotherapies, focusing on antigen discovery and T-cell receptor engineering for T-cell therapies. Guiding us through the field is Jim Heath, President of the Institute for Systems Biology in Seattle, where he runs the Heath Lab, investigating fundamental immunology, and infectious and chronic diseases. Jim discusses the computational models and wet lab techniques he uses to characterize T cells, the importance of targeting a balanced immune response with immunotherapies and more in this podcast recorded at AACR 2024 (5th–10th April 2024; San Diego, CA, USA).Contents:Introductions: 00:00-02:00Intro to cancer vaccines and T-cell therapies: 02:00-04:00Antigen detection and validation in T-cell therapies: 04:00-05:20Wet lab and computational techniques for antigen detection: 05:20-09:15The importance of a balanced immune response to cancer immunotherapies: 09:15-10:30Technological developments in antigen detection: 10:30-13:45 Tips for best practice when conducting T-cell receptor design 13:45-15:40What is one thing you would like to see change in the field of antigen detection and T-cell receptor engineering? 15:40-16:30 Designing the path towards a more balanced immune response from immunotherapies 16:30-19:40
4. Cytokines: from therapeutics to diagnostics
26:11||Season 5, Ep. 4In this episode of Talking Techniques, Ritwika Biswas, Field Application Scientist at Sino Biological US Inc. (PA, USA), discusses the use of cytokines in immunotherapy. Ritwika details the role of cytokines in the body, before going on to discuss how they can be used as therapeutics and to guide treatment decisions. Ritwika also shares how she thinks these proteins will be used in the future.Contents· Introduction: 00:00–01:35· The role of cytokines in the body: 01:35–02:52· Immune regulation and signaling: 02:52–05:40· Cytokine interactions and networks: 05:40–08:42· Modulating cytokine activity for therapeutic purposes: 08:42–12:35· The influence of cytokines on immunotherapy outcomes: 12:35–16:04· Using cytokines to predict treatment responses and guide immunotherapy decisions: 16:04–20:44· The importance of standardizing and validating cytokine diagnostic assays: 20:44–24:36· The future of cytokines in immunotherapy: 24:36–26:11
3. Spatial analysis of the immune-cell-surface proteome at a single-cell resolution
23:58||Season 5, Ep. 3The cell-surface proteome plays a critical role in immune-cell function; however, our ability to examine its interactions and spatial organization has previously been limited by available proteomic techniques. This episode explores the function of immune-cell membrane proteins and how the latest developments in spatial proteomics have enabled more detailed interrogation of these proteins and their spatial relationships.Our guest, Hanna van Ooijen, Immunology Application Scientist at Pixelgen Technologies guides us through the field, revealing a new technique that enables spatial analysis of the cell-surface proteome at a single-cell resolution and highlighting some exciting discoveries that it has facilitated.Contents:Introductions: 00:00-01:40Introducing Molecular Pixelation: 01:40-02:15Example applications of Molecular Pixelation: 02:15-03:20The role of membrane proteins in immune cell function: 03:20-07:25Traditional techniques to investigate cell membrane proteins: 07:15-10:20Recent improvements in investigative technology and our understanding of immunology: 10:20-11:10Challenges associated with current technologies: 11:10-13:50How Molecular Pixelation can address these challenges: 13:50-15:25Molecular Pixelation workflow: 15:25-17:55Tips for best practice when using molecular pixelation: 17:55-19:30Exciting discoveries using Molecular pixelations: 19:30-21:00Potential implications of molecular pixelation for the future of immunology: 21:00-24:00
2. Investigating the neurological pathways underlying vocal communication
34:27||Season 5, Ep. 2In this episode of Talking Techniques, we catch up with Michael Long, Principle Investigator of the Long Lab at New York University (NY, USA), where he investigates the neural circuits that underlie vocal communication.Through the examination of animal models, from songbirds to the rare singing mice of Costa Rica, with cutting-edge imaging techniques Michael reveals fascinating insights into vocal communication. We also discuss his human experiments, working alongside neurosurgeons, with emerging electrophysiological probes to monitor the neural activity of participants as they speak and interact, ultimately revealing how this research could begin to provide solutions for neurological conditions impacting communication, such as autism.Contents:Introduction: 00:00 – 01:40Investigating neural circuits underlying vocal communication: 01:40 – 04:15Techniques to explore animal models of vocal communication: 04:15 – 06:25The impact of cooling brain regions on songbird singing: 06:25 – 07:50The techniques used to investigate animal models: 07:50 – 12:20Songbirds: 07:50 – 09:45The singing mouse: 10:00 – 12:20Investigating neural circuits in humans during speech: 12:20 – 16:30Investigating neural circuits in humans during conversation: 16:30 – 19:00Moving beyond neural area identification towards understanding neural pathways and mechanisms: 19:00 – 21:40Navigating neuropixels, big data and safety: 21:40 – 26:10If there was one thing you could ask for to help you better understand these pathways, what would it be? 26:10 – 27:55The experience of working with patients undergoing neurosurgery: 27:55 – 30:30The potential impact on speech disorders and autism: 30:30 – 33:15
1. Rare disease and pharmacogenomics
20:18||Season 5, Ep. 1Launching our fourth season of Talking Techniques, this episode, supported by the University of Cincinnati (OH, USA) we delve into rare disease research and pharmacogenomics, their intersection and the key techniques used to explore them.Guiding us through these fields is Brenna Carey, an Assistant Professor at Cincinnati Children’s Hospital Medical Center whose research focuses on rare disease pathogenesis, diagnostics and therapeutic development and who also runs key courses on the University’s Pharmacogenomics and Drug Discovery Masters degree programs.Contents:Introduction: 00:00-01:15An introduction to pulmonary alveolar proteinosis (PAP) and rare lung diseases 01:15-03:50Techniques to investigate the pathogenesis of PAP: 03:50-05:30Developing diagnostics and therapeutics for PAP: 05:30-08:20The importance of pharmacogenomics in drug development: 08:20-11:25Key techniques and approaches in pharmacogenomics: 11:25-13:00Emerging trends in pharmacogenomics: 13:00-15:05Key takeaways from your pharmacogenomics course: 15:00-18:00What would you ask for to improve our understanding of pharmacogenomics? 18:00-20:15This episode is supported by the University of Cincinnati Online